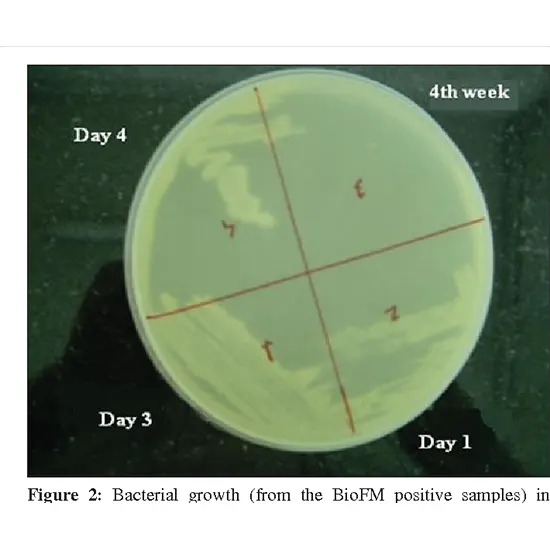

Book CSF For AFB Culture MGIT Appointment Online Near me at the best price in Delhi/NCR from Ganesh Diagnostic. NABL & NABH Accredited Diagnostic centre and Pathology lab in Delhi offering a wide range of Radiology & Pathology tests. Get Free Ambulance & Free Home Sample collection. 24X7 Hour Open. Call Now at 011-47-444-444 to Book your CSF For AFB Culture MGIT at 50% Discount.
Although CSF for AFB testing may be used to detect a variety of acid-fast bacilli, it is most frequently used to detect active tuberculosis (TB) infection caused by Mycobacterium tuberculosis, the most medically significant AFB.
AFB testing can identify a variety of acid-fast bacilli. However, it is most frequently used to spot active tuberculosis (TB) infections brought on by Mycobacterium tuberculosis, the most significant AFB from a medical standpoint.
All vertebrates have this clear, colourless bodily fluid, which is found in the tissue that covers their brains and spinal cords. Any bilateral animals' bodily fluid detected outside the cells is replaced.
To aid in diagnosing tuberculosis (TB) and other Mycobacterium species infections, often known as acid-fast bacilli (AFB), in those at risk of contracting mycobacterial illnesses; to track the efficacy of treatment.
Recommend AFB stain in high-risk patients such as those who are immunocompromised, are alcoholics or have recently come into contact with TB patients.
1. Make a smear of the sample culture and heat fix it over blue heat on a clean, sterile microscopic slide.
2. Pour and flood the smear with carbon Fuschia, then heat it slowly until fumes appear.
3. Let it sit for five minutes, then rinse it off with gently running water from the faucet.
4. Add 20% sulfuric acid and wait a minute or two. Continue doing this until the smear turns pink.
5. Use water to rinse the acid off.
6. Cover the stain with methylene blue dye, let it sit for a few minutes, and then rinse it with water.
7. Let the stain air dry before checking it with an oil immersion lens.
Positive:
The acid-fast bacilli are red colour rods, and the background is blue. This is a positive result.
2. When these Rods are seen, they indicate active tuberculosis.
3. The culture may confirm a positive AFB stain.
A negative result indicates that: 1. There is no infection.
2. There weren't enough bacteria to be seen under a microscope.
3. There may be additional causes for the symptoms.
| Test Type | CSF For AFB Culture MGIT |
| Includes | CSF for AFB Culture MGIT (Nephrology) |
| Preparation | |
| Reporting | Within 24 hours*
|
| Test Price |
₹ 1125
|

Early check ups are always better than delayed ones. Safety, precaution & care is depicted from the several health checkups. Here, we present simple & comprehensive health packages for any kind of testing to ensure the early prescribed treatment to safeguard your health.